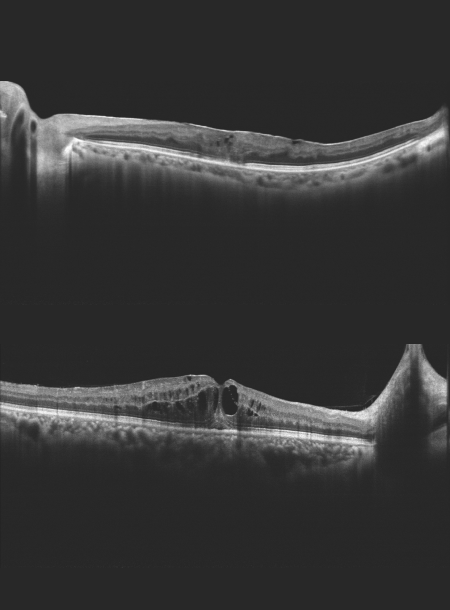
Spectral domain OCT

Оптичний Когерентний Томограф Mocean 3000 Moptim

Mocean 3000 – це ОКТ з усіма необхідними функціями дослідження як сітківки, так і переднього відрізка ока.
Основні характеристики
- Висока якість ОКТ-зображення
- Глибина сканування 3 мм показує деталізоване зображення склоподібного тіла, сітківки та судинної оболонки
- Зображення сітківки в режимі реального часу під кутом 45° SLO
- Відстеження сітківки на основі SLO
- Сканування від кута до кута 16 мм
- Комплексний аналіз сітківки, глаукоми та рогівки
Функції програмного забезпечення для аналізу завжди актуальні та безкоштовні для оновлення (за винятком модуля OCTA).

Висока якість SLO в реальному часі + відстеження руху очей
Mocean® 3000 одночасно отримує ОКТ-зображення і зображення очного дна під кутом 47 градусів на основі скануючого лазерного офтальмоскопа (SLO), забезпечуючи огляд сітківки в режимі реального часу, що дозволяє легко локалізувати ділянку ураження ще до отримання зображення.
Щоб мінімізувати викривлення, спричинені зміщенням очей і мікросаккадами, Mocean® 4000 використовує систему відстеження очей на основі SLO.

Аналіз від кута до кута 16 мм
Сканування від кута до кута 16 мм переднього відрізка з аналізом даних.

Режим глибокої судинної томографії (DCI)
Використання глибокої судинної томографії для виявлення неоваскуляризації судинної оболонки.

Комплексний аналіз програмного забезпечення та безкоштовне оновлення
Система Mocean® 3000 пропонує 8 моделей сканування, які допоможуть вам підвищити ефективність діагностики:
Сітківка (HD лінійне та шестилінійне сканування, мульти, 3D куб),
Глаукома (Диск глаукоми для аналізу ONH, сканування макулярної області для аналізу GCC),
Рогівка (HD лінійне та шестилінійне сканування, сканування від кута до кута)
Технічні характеристики
ОКТ візуалізація | |
| Метод | Спектральна область ОКТ |
| Оптичне джерело | Суперлюмінесцентний діод (SLD), 840 нм |
| Швидкість сканування | 50 000 А-сканів/с |
| Осьова роздільна здатність (оптична) | 5 мкм (оптична), 2,7 мкм (цифрова) |
| Повздовжня роздільна здатність | 15 мкм (оптична), 3 мкм (цифрова) |
| Глибина А-сканування | 3,1 мм |
| Діапазон діоптрій | -20 до +20 D |
| Шаблони сканування | Макулярна область: Лінійне сканування HD (6 / 12 мм), 3D-сканування (6 мм x 6 мм), 6-рядкове радіальне сканування, Multi (X-Y: 5 x 5) Диск: 3D-сканування (6 мм x 6 мм) Передній відрізок: HD-лінійне сканування (6/16 мм), 6-лінійне радіальне сканування |
Зображення очного дна | |
| Метод | Лінійна скануюча лазерна офтальмоскопія (LSLO) |
| Мінімальний діаметр зіниці | 3,0 мм |
| Поле зору | 45 ± 1° |
Пристрій | |
| Зовнішні розміри | 532 мм (Д) x 360 мм (Ш) x 540 мм (В) |
| Вага | 30,5 кг |
| Частота | 50 Гц - 60 Гц |
| Вхідна потужність | 90 ВА |